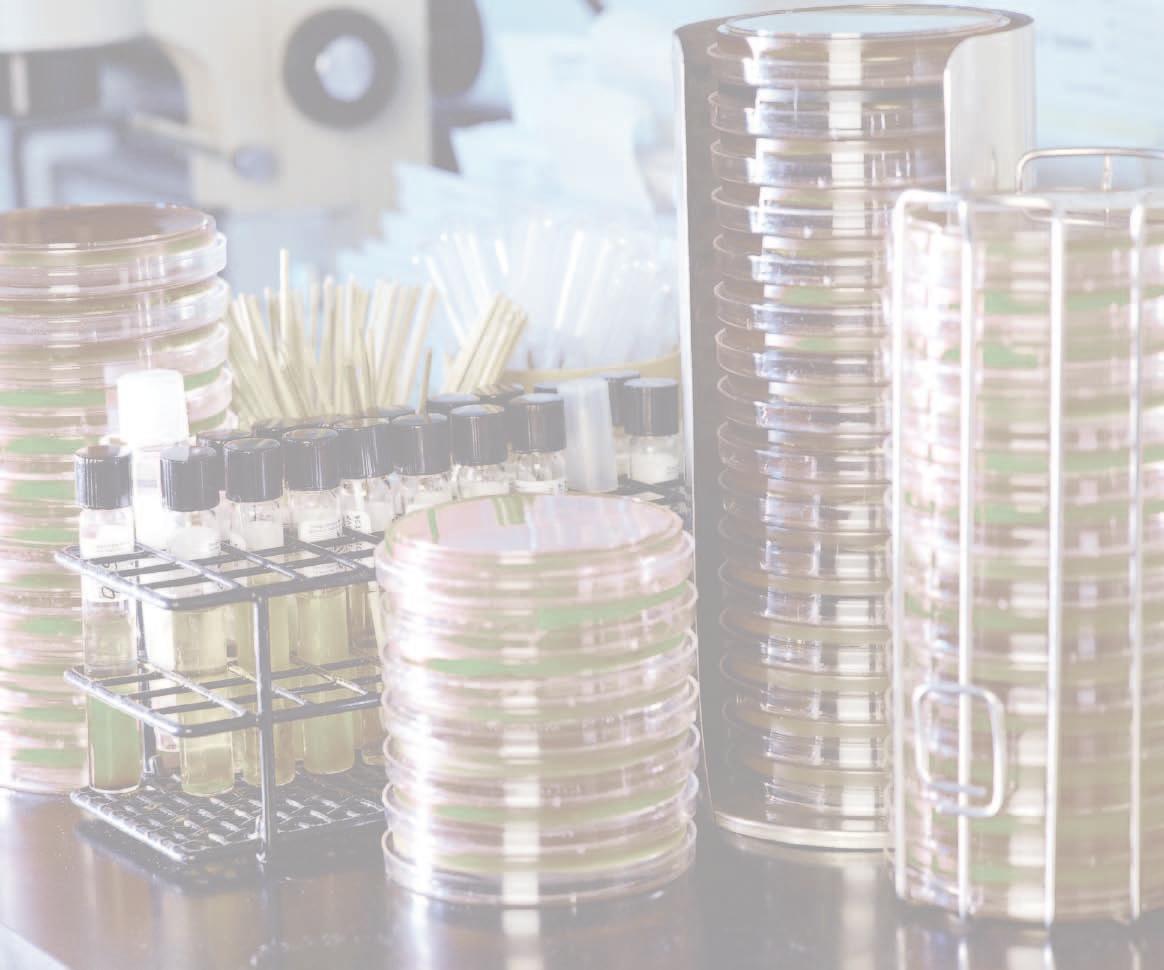

Präzisionstechnik




Miniaturtische Serie PROmech

Parker Werk in Offenburg, Deutschland Fertigung und Service Präzisionskomponenten in Europa













Miniaturtische Serie PROmech

Parker Werk in Offenburg, Deutschland Fertigung und Service Präzisionskomponenten in Europa

www.parker-eme.com/PROMECH
www.parker-eme.com/LP28
•
•
•
•
•
•
Miniaturprofil
Optimales Längen-/Hubverhältnis
Verfahrwege von 5 mm bis 500 mm
Komplett vormontiertes Paket
Mehrachsplattform
Mit integriertem Motor
Eigenschaften:
•
Miniatur-Querschnitt
(28 mm x 28 mm)
• spindel
Antriebsstrang mit Hochleistungs-
• Spindelsteigung
•
1 mm, 3 mm, 10 mm, und 25,4 mm

Kugelumlaufführung
Verfahrwege zwischen 5 mm und
• 500 mm millimetergenau wählbar
NEMA 11 oder NEMA 17 Schritt-
• motoren standardmäßig integriert
• Endsensoren
Frei einstellbare Null- und
Die Positioniertische der PROmech Familie wurden speziell für Maschinenbauer entwickelt, die einfache Positionierlösungen für die Instrumentierung und leichte Industrieanwendungen benötigen. Sie bieten diesen eine komplette Positionierlösung zu einem erschwinglichen Preis zur Integration in ihre Geräte.
Der PROmech LP28 ist eine kompakte Positionierachse; ihre Vollständigkeit ermöglicht dem Maschinenbauer, den zeitlichen Aufwand für die Auswahl der Komponenten und die Konstruktion zu reduzieren. Außerdem minimieren die PROmech Positionierer den Anpassungsaufwand, weil diese Konstruktion bereits umfangreich getestet wurde. In der Summe helfen diese Vorteile Konstruktionsteams, knappe Projektfristen einzuhalten und reduzieren die »Time to Market«
Wenn ein System in die Produktion geht, helfen die PROmech Positionierer, sowohl Kosten als auch Montagezeit einzusparen. Eine Linearachse von Grund auf zu bauen erfordert die Beschaffung, Teileverfolgung,
Warenannahme, Lagerwirtschaft, Kommissionierung, Montage und den Test von ungefähr einem Dutzend Teilen. Jedes Mal, wenn ein Teil während dieses Prozesses „angefasst“ werden muss, werden Ressourcen verbraucht und versteckte Kosten bzw. Zeitaufwand entstehen. Statt einem Dutzend Teilen, ist ein PROmech Positionierer nur ein einziges Teil, das von einem einheimischen Lieferanten mit kurzen Durchlaufzeiten bezogen wird. PROmech Positionierer sind leicht zu beschaffen und schnell einzubauen, wenn sie erst einmal in der Werkstatt sind.
Mehrachssysteme über den Einachspositionerer hinaus erfordern viele Anwendungen XY- oder XYZ-Konfigurationen. PROmech Positionierer sind konstruktiv für die Mehrachsmontage ausgelegt und verfügen über entsprechendes Zubehör. Zur weiteren Reduzierung ihrer Montagezeiten, bietet Parker PROmech™ Systeme aus Achsen, die nach ihren Spezifikationen montiert und ausgerichtet werden.
Ob Sie nun 100 Achsen oder 10 000
Achsen pro Jahr abnehmen, die PROmech Serie von Parker bietet Ihnen die nötige Flexibilität, Verlässlichkeit und einfache Handhabung zur Erreichung Ihrer Geschäftsziele.
Das PROmech Design basiert auf einem stranggepressten Aluminiumprofil, das optisch ansprechend, funktional und durchbiegefest ist. Die innere Konstruktion verfügt über eine integrierte Antriebsspindel, Spindelmutter und unabhängige vorgespannte Axiallager sowie Wellenkupplung und Motor. Ein zusätzliches Linearlager kann verwendet werden, um schwere oder freitragende Nutzlasten zu stützen. Die Klemmpratzemontage macht die Inbetriebnahme
extrem schnell. Schließlich kann man auch in den T-Nuten Endschalter und Maschinennullinititatoren frei verschiebbar montieren, die durch einen Magneten im Läufer ausgelöst werden.
Der PROmech LP28 ist für den Transport kleiner Nutzlasten über Strecken zwischen 5 mm und 500 mm gebaut. Der LP28 wird üblicherweise in der Biotechnologie, Medizintechnik und in der Halbleiterindustrie eingesetzt, ist jedoch nicht auf diese Bereiche
beschränkt. In typischen Anwendungen werden Nutzlasten von 0,5 bis 0,9 kg, wie z.B. Microplatten, Reagenzgläser und kleine Spritzenpumpen transportiert. In Prüfanwendungen eignet sich der LP28 hervorragend als Focusachse zur Positionseinstellung einer Kamera, Optik oder Nutzlast. Das geringe Gewicht des LP28 prädestiniert ihn auch für mobile Geräte.
Schrittmotor
In den Positionierer integriert, um die Anwendung und Installation einer kompletten Bewegungslösung zu vereinfachen.
Motorkupplung Integriert, um Platz zu sparen und um die Lebensdauer zu erhöhen.
Antriebsstrang mit Leitspindel
Die Spindel hat eine lange Lebensdauer und bietet etlichen Steigungsoptionen, um den Anforderungen einer Anwendung gerecht zu werden.
Option Bandabdeckung
Polyethylen-Bandabdeckung zum Schutz vor eindringenden Partikeln erhöht die Lebensdauer und hält die Achse frei von Verschmutzungen (nicht abgebildet).
Axiallagerset
Unabhängig von den Motorlagern für präzise, verlässliche Bewegung ohne Risiko für den Motor.
Stranggepresstes Aluminiumprofil

Bietet strukturelle Steifigkeit, ein optisch ansprechendes Äußeres und Funktionalität mit T-Nuten zur Montage und Befestigung von Anbauteilen.
Maschinennull- und Endschalter
Können an der äußeren T-Nut montiert werden und sind über den gesamten Verfahrweg verschiebbar (nicht abgebildet).
Lineare Präzisionslager
Garantieren hohe Laufruhe und Geradheit beim Transport von Nutzlasten während der gesamten Lebensdauer des Positionierers.
T-Nuten
Zur Montage von Anbauteilen inkl. Maschinennull- und Endschaltern.
Um die Anwendung zu vereinfachen, wurden die unterschiedlichen Leistungsaspekte des Positionierers wie Motordrehmoment, Motorgeschwindigkeit, Spindelwirkungsgrad, Reibung, Sicherheitsmarge etc. in diesen Geschwindigkeits-/Vorschubdiagrammen zusammengeführt.
Um eine Auswahl zu treffen, benutzen Sie zuerst die X-Achsen-Skala der einzelnen Grafiken, um eine Spindelsteigung zu finden, die die gewünschte Spitzengeschwindigkeit liefert. Suchen Sie dann mit Hilfe des entsprechenden Spindelsteigungsdiagramms den Motor heraus, der genügend Moment aufbringt, um den benötigten Vorschub zum Heben bzw. Beschleunigen der Nutzlast zu liefern. Die NEMA 11 Schrittmotorkurven (Optionen M11xx und M13xx) gehen von einer 24 VDC Busspannung bei 0,67 A aus, die NEMA 17 Schrittmotoren (Optionen M71xx) von einer 48 VDC Busspannung bei 1,14 A für seriellen Betrieb und 2,28 A für parallelen Betrieb. Alle Grafiken sind wegen mechanischer Beschränkungen auf 45 N Vorschub begrenzt. Sie sollten, vor allem bei den Spindeln mit 1 mm Steigung (Optionen D01), darauf achten, die Achse nicht im Verfahrwegsende festzufahren, da diese Motor-Spindel-Kombination erheblichen Vorschub erzeugen kann. Alle Kurven berücksichtigen eine Sicherheitsmarge von 10 %. Die „maximale empfohlene Geschwindigkeit“ basiert auf einer maximalen Motorgeschwindigkeit von 15 s-1. Generell können die Motoren schneller als 15 s-1; drehen, bei ca. 20 s-1 tritt jedoch eine Resonanz auf, die nachteilige und unvorhersehbare Effekte auf das Motordrehmoment habt. Für Applikationen, die höhere Geschwindigkeiten erfordern, empfiehlt Parker eine schnellere Steigung oder einen Servomotor. Anwendungen, die einen Schrittmotor über der empfohlenen Grenze einsetzen, müssen vom Nutzer komplett getestet und entsprechend angepasst werden.
NEMA 11 3-Stack (Option M13xx)
NEMA 11 1-Stack (Option M11xx)
NEMA 17 1-Stack - seriell (Option M71xx)
NEMA 17 1-Stack - parallel (Option M71xx)



Millimetergenauer Verfahrweg
Da der LP28 ein Miniaturtisch ist und oft in winzige Lücken passen muss, ist der Verfahrweg des LP28 milli-
metergenau zwischen 5 und 500 mm wählbar. Dies bietet größtmögliche Flexibilität und erlaubt Konstruktionen mit genau dem nötigen Verfahrweg bei minimaler Gesamtlänge.





Unabhängige Axiallager
Da große Zuverlässigkeit und lange Lebensdauer wichtige Erfordernisse der OEM-Konstruktion darstellen, verfügt der LP28
über ein Paar unabhängiger Axiallager zur Aufnahme der Axiallasten des Positionierers.
Einige Miniaturantriebsstränge von Mitbewerbern nutzen die Radiallager im Schrittmotor, um den Rotor zu beherbergen, die thermische Ausdehnung beim Erwärmen des Motors auszugleichen und die Axiallasten aufzunehmen, die von der Anwendung erzeugt werden. In manchen
Fällen ist dies akzeptabel, kann sich aber irgendwann als Sicherheitsrisiko erweisen. Die Lagerkonstruktion des LP28 lässt Axiallager Axiallager und Motorlager Motorlager sein, was wiederum eine bessere Verlässlichkeit und Lebensdauer bedeutet.
Motorkupplung
Eine Motorkupplung ist in die Konstruktion des PROmech integriert. Das innovative Design minimiert die Anzahl der Bauteile und die Gesamtlänge und bietet nötigenfalls das Maß an Flexibilität für einen speziellen Motor.
PROmech bietet eine stabile Polyesterabdeckung, die sich nicht ausdehnt oder abnutzt, und der Leitspindel und den inneren Lagern Schutz bietet. Die Abdeckung entspricht Schutzklasse IP30 und passt farblich zum schwarzen Profil. Die Bandabdeckung wird unter den Lageroptionen bestellt und erhöht die Gesamtlänge leicht durch den verlängerten Läufer.
Der LP28 ist so konstruiert, dass er in XY- und kartesischen Anordnungen nur mit Klemmpratzen montiert werden kann. Z-Achsen mit kurzem Verfahrweg können ebenfalls nur mit Klemmpratzen angebaut werden, während längere Verfahrwege einen Standard Z-Winkel erfordern.
Die Installation des LP28 ist mit Klemmpratzen, die überall entlang des Profils angebracht werden können und somit Montageflexibilität bieten, sehr einfach. Die nockenförmigen Klemmpratze können außen am Positionierer "lose" angebracht werden. Dadurch kann man die Klemmpratzen schnell und einfach platzieren und problemlos anziehen. Nun kann der Positionierer ausgerichtet und die Klemmpratzen in der unteren Nut angezogen werden. Klemmpratzen sind als Zubehör im Viererpack (Artikelnummer 002-2530-01) erhältlich. Dies ist ideal für Achsen mit relativ kurzem Verfahrweg. Für OEMs gibt es die Klemmpratzen auch in der Großpackung (Artikelnummer 0022531-01).
Die PROmech Serie bietet 4 Standard-Spindelsteigungen: 1 mm, 3 mm, 10 mm und 25,4 mm Steigung. Ob die Anwendung

langsam und präzise, lang und schnell oder irgendetwas dazwischen ist, diese Optionen erlauben es Ihnen, den Antriebsstrang genau auf ihre Anwendung auszulegen.
Die PROmech Serie verfügt über eine Reihe von Standardmotoren. Für die meisten Anwendungen passen die NEMA 11 Motoren problemlos. Diese sind in vielen verschiedenen Baulängen erhältlich. Die Motoren können eine hintere Welle zur Encodermontage oder zur manuellen Positionierung haben. Sie können außerdem zwischen 0,3 m offenen Enden für den Motoranschluss oder einem 3 m langen Kabel wählen. Außerdem erfordern die schnelleren Leitspindeloptionen die höheren Momentenkapazitäten der Standard NEMA 17 Stepper.



Rotative Encoder an der Rückseite des Motors sind verfügbar.

Die PROmech Serie bietet 2 Standard-Lageroptionen: eine einzelne Schiene mit einem Laufwagen oder mit zwei Laufwagen. Diese Optionen bieten die Flexibilität, das Linearlagersystem genau auf die Anwendung abzustimmen.
Maschinennullinitiator oder Endschalter Optionen
Maschinennull- und Endsensoren sind als Standardoption verfügbar. Diese werden seitlich an der Achse in den T-Nuten befestigt und werden von einem Magneten im Läufer aktiviert. Vier Sensorentypen
mit allen Öffner-, Schließer-, NPNund PNP- Varianten sind verfügbar. Diese Sensoren umfassen auch 3,0 m Kabel. Die Maschinennullsensoroptionen umfassen einen Sensor und das Montagematerial. Die Endschalteroptionen umfassen zwei Sensoren und das Montagematerial.
Eingangsspannung 10-30 VDC Spannungsabfall ≤ 2,5 V Dauerstrom 100 mA


Elektrische Absicherung Kurzschluss, Verpolschutz, Einschaltpulsunterdrückung
Gehäuse Polyamidgehäuse mit PVC-Kabelmantel in Schutzklasse IP67
Kabelfarben braun – Netz (+); schwarz – Signal; blau – Erde (-)
Kabellänge 3,0 m, offene Enden Bestell-
Abmessungen PROmech LP28
Ein Laufwagen (Option G21)
Verfahrweg + 85,0 (ohne Bandabdeckung) + 102,0 (mit Bandabdeckung) (6) Montageborhungen Gewinde M3x0.5 Zentriert 35,0 45,0
NEMA 17 Motoroption (Option M71xx)
11,5 6,8
23,0 5,8 Zentriert 35,0
9,9 Wellen Ø 5,0
"A" 42,2
23,0 10,3
21,1
42,2 21,1
Zubehör Endschalter Zubehör Klemmprofil
Optionales Klemmpro Optionaler EndMaschinennullinitiator M3x12mm Schraube empfohlen 35,0 42,0 17,5 5,0 T-Nut für M2 Nutenstein 3,0m Kabel mit offenen Enden Nur für Klemmpro keine Nut 31,7 15,0 15,5 21,8 25,8 Bauform "A" [mm] Strom [A/Phase] Moment [Nm] Widerstand [Ω/phase] Induktivität [mH] Massenträgheitsmoment [kgmm2] Eigengewicht [kg] Kabelfarbe M11xx 31,50,67Spitze/0,5Dauer 0,065,63,4 0,90,11 A+ rot A- schwarz B+ weiß B- grün M12xx 44,50,67Spitze/0,5Dauer 0,107,14,81,280,14 M13xx 50,60,67Spitze/0,5Dauer 0,148,66,71,830,20 M71xx (Direkt)501,14Spitze/0,8Dauer 0,4011,0914,293,30,18 siehe Handbuch M71xx (Parallel)502,280,402,773,573,30,18
www.parker-eme.com/LD28
•
Miniaturprofil
Unabhängiges Axiallager-Set
•
• Hoher Vorschub pro Baugröße
•
•
•
Schritt- oder Servomotor

Verfahrweg von 5 mm bis 300 mm
Spielausgleich
Eigenschaften:
• (28 mm x 28 mm)
Miniatur-Querschnitt
• Hochleistungsspindel
•
•
Antriebsstrang mit
1 mm, 3 mm, 10 mm, und 25,4 mm
Spindelsteigung
Spielfreie Muttern
Verfahrwege zwischen 5 mm und
• 300 mm millimetergenau wählbar

NEMA 11 oder NEMA 17 Schritt-
• motoren standardmäßig integriert
• tes Axiallager-Set für lange
Unabhängiges, vorgespann-
Lebensdauer
Die Positioniertische der PROmech
Familie wurden speziell für Maschinenbauer entwickelt, die einfache Positionierlösungen für die Instrumentierung und leichte Industrieanwendungen benötigen. Sie bieten diesen eine komplette Positionierlösung zu einem erschwinglichen Preis zur Integration in ihre Geräte.
Der PROmech LD28 ist eine kompakte Positionierachse; ihre Vollständigkeit ermöglicht dem Maschinenbauer, den zeitlichen Aufwand für die Auswahl der Komponenten und die Konstruktion zu reduzieren. Außerdem minimieren die PROmech Positionierer den Anpassungsaufwand, weil diese Konstruktion bereits umfangreich getestet wurde. In der Summe helfen diese Vorteile Konstruktionsteams, knappe Projektfristen einzuhalten und reduzieren die »Time to Market«.
Wenn ein System in die Produktion geht, helfen die PROmech Positionierer, sowohl Kosten als auch Montagezeit einzusparen. Eine Linearachse von Grund auf zu bauen erfordert die Beschaffung, Teileverfolgung, Warenannahme, Lagerwirtschaft, Kommissionierung, Montage und den Test von ungefähr einem Dutzend
Teilen. Jedes Mal, wenn ein Teil während dieses Prozesses „angefasst“ werden muss, werden Ressourcen verbraucht und versteckte Kosten bzw. Zeitaufwand entstehen. Statt einem Dutzend Teilen, ist eine PROmech Achse nur ein einziges Teil, das von einem einheimischen Lieferanten mit kurzen Durchlaufzeiten bezogen wird. PROmech Achsen sind leicht zu beschaffen und schnell einzubauen, wenn sie erst einmal in der Werkstatt sind.
Der PROmech LD28 ist für den Vorschub kleiner Nutzlasten über
Strecken zwischen 5 mm und 300 mm gebaut. Der LD28 wird üblicherweise in der Biotechnologie, Medizintechnik und in der Halbleiterindustrie eingesetzt, ist jedoch nicht auf diese Bereiche beschränkt. Typische Anwendungen sind z.B. Spritzenpumpen und Positioniertische. Das geringe Gewicht des LD28 prädestiniert ihn auch für mobile Geräte.
Über Standardkonfigurationen hinaus, können die PROmech LD28 Achsen kundenspezifisch angepasst werden, um die einzigartigen Anforderungen einer bestimmten Großserien-Anwendung zu erfüllen. Diese Modifikationen können die Kosten weiter reduzieren und könnten spezielle Motoren (Schritt-, Servo- oder DCMotor), spezielle Spindeln (feinere Steigung, Kugelumlaufspindeln, spezielle Muttern etc.) und Vorbereitung für spezielle Umgebungen (Vakuum, hohe Temperaturen etc.) umfassen, um nur Einige zu nennen.
Ob Sie nun 10 Achsen oder 10 000 Achsen pro Jahr abnehmen, die PROmech Serie von Parker bietet Ihnen die nötige Flexibilität, Verlässlichkeit und einfache Handhabung zur Erreichung Ihrer Geschäftsziele.
Axiallagerset
Unabhängig von den Motorlagern für präzise, verlässliche Bewegungen ohne Risiko für den Motor.
Schrittmotor

In den Positionierer integriert, um die Anwendung und Installation einer kompletten Bewegungslösung zu vereinfachen.
Antriebsstrang mit Leitspindel
Die Spindel hat eine lange Lebensdauer und bietet etlichen Steigungsoptionen, um den Anforderungen einer Anwendung gerecht zu werden.
Motorkupplung
Integriert, um Platz zu sparen und um die Lebensdauer zu erhöhen.
Polymer-Spindelmutter
Inklusive Spielausgleich zur Verbesserung der bidirektionalen Wiederholgenauigkeit bei langer Lebensdauer.
Da große Zuverlässigkeit und lange Lebensdauer wichtige Erfordernisse der OEM-Konstruktion darstellen, verfügt der LD28 über ein Paar unabhängiger Axiallager zur Aufnahme der Axiallasten des Positionierers.
Einige Miniaturantriebsstränge von Mitbewerbern nutzen die Radiallager im Schrittmotor, um den Rotor zu beherbergen, die thermische Ausdehnung beim Erwärmen des Motors auszugleichen und die Axiallasten aufzunehmen, die von der Anwendung erzeugt werden. In manchen Fällen ist dies akzeptabel, kann sich aber irgendwann als Sicherheitsrisiko erweisen. Die Lagerkonstruktion des LD28 lässt Axiallager Axiallager und Motorlager Motorlager sein, was wiederum eine bessere Verlässlichkeit und Lebensdauer bedeutet.
Eine Motorkupplung ist in die Konstruktion des PROmech integriert. Die innovative Konstruktion minimiert die Anzahl der verwendeten Teile sowie die Gesamtlänge. Und sie bietet gegebenenfalls ein gewisses Maß an Flexibilität, wenn ein spezieller Motor benötigt wird.
Die PROmech Serie bietet 4 Standard-Spindelsteigungen: 1 mm, 3 mm, 10 mm und 25,4 mm Steigung. Ob Ihre Anwendung langsam und präzise, lang und schnell oder irgendetwas dazwischen ist, diese Optionen erlauben es Ihnen, den Antriebsstrang genau auf ihre Anwendung auszulegen.

Die Installation des LD28 auf ist durch Klemmpratzen oder T-Nuten für die Montage auf Oberflächen, die parallel zur Achse sind oder Gewindemontage auf Oberflächen, die rechtwinklig zur Achse sind, sehr einfach. Die nockenförmigen Klemmpratzen können vorab schon „lose“ angebracht werden und sind somit dann schnell und einfach zu platzieren und problemlos anzuziehen. Dann kann die Achse ausgerichtet werden und die Klemmpratzen in der unteren Nut angezogen werden. Klemmpratzen sind als Zubehör im Viererpack (Art.Nr. 002-2530-01) erhältlich oder als Großpackung (Art.-Nr. 002-2531-01) erhältlich. Die T-Nut erlaubt es, zu Montagezwecken einen Stift durch die Oberfläche in einen T-Nutenstein zu stecken. Hierfür verfügt der LD28 über vier M2,5 Gewindebohrungen, die im Rechteck mit Kantenlänge 23,1 mm angeordnet sind.
Die PROmech Serie verfügt über eine Reihe von Standardmotoren. Für die meisten Anwendungen passen die NEMA 11 Motoren problemlos. Diese sind in vielen verschiedenen Baulängen erhältlich. Die Motoren können eine hintere Welle zur Encodermontage oder zur manuellen Positionierung haben. Sie können außerdem zwischen 0,3 m offenen Enden für den Motoranschluss oder einem 3 m langen Kabel wählen. Außerdem erfordern die schnelleren Leitspindeloptionen die höheren Momentenkapazitäten der Standard NEMA 17 Stepper.
Encoder Optionen


Rotative Encoder an der Rückseite des Motors sind verfügbar.




Da der LD28 eine Miniaturachse ist und oft in winzige Lücken passen muss, ist der Verfahrweg des LD28 millimetergenau zwischen 5 und 300 mm wählbar. Dies bietet größtmögliche Flexibilität und erlaubt Konstruktionen mit genau dem nötigen Verfahrweg bei minimaler Gesamtlänge.
Wählen Sie aus allen unten aufgeführten nummerierten Feldern ihre Wunschoption aus, um einen kompletten Bestellschlüssel zu erstellen.
Bestellinformation PROmech Serie 1 2 3 4 5 6 7
Bestellbeispiel LP28T0050D01G31M1111H3 L2
1Baureihe LP28
2Verfahrweg
Txxxx Bitte Länge in mm angeben
3Antrieb
D00 Mitlaufende Achse ohne Antrieb
D01 1 mm Leitspindel (1)
D03 3 mm Leitspindel
D10 10 mm Leitspindel
D26 25,4 mm Leitspindel (2)
4Führungssysteme
G21 Linearschiene mit einem Laufwagen, keine Abdeckung
G22 Linearschiene mit einem Laufwagen, mit Abdeckung
G31 Linearschiene mit zwei Laufwagen, keine Abdeckung
G32 Linearschiene mit zwei Laufwagen, mit Abdeckung
5Motor
M1111 Schrittmotor, NEMA 11, 1 Stack, 0,3 m Leitung (2)
M1112 Schrittmotor, NEMA 11, 1 Stack, 3 m Kabel (2)
M1321 Schrittmotor, NEMA 11, 3 Stack, hintere Welle, 0,3 m Leitung (2)
M1322 Schrittmotor, NEMA 11, 3 Stack, hintere Welle, 3 m Kabel (2)
M7122 Schrittmotor, NEMA 17, 1 Stack, hintere Welle, 3 m Kabel (1)
6Maschinennullsensor (3)
H1 ohne
H2 Öffner, NPN, 3,0 m Kabel mit offenen Enden
H3 Schließer, NPN, 3,0 m Kabel mit offenen Enden
H4 Öffner, PNP, 3,0 m Kabel mit offenen Enden
H5 Schließer, PNP, 3,0 m Kabel mit offenen Enden
7Endsensoren (Menge 2) (3)
L1 ohne
L2 Öffner, NPN, 3,0 m Kabel mit offenen Enden
L3 Schließer, NPN, 3,0 m Kabel mit offenen Enden
L4 Öffner, PNP, 3,0 m Kabel mit offenen Enden
L5 Schließer, PNP, 3,0 m Kabel mit offenen Enden
(1) D01 nicht verfügbar mit M7xxx
(2) D26 nicht verfügbar mit M1xxx
(3) Tische mit einem Verfahrweg von 75 mm oder kürzer haben ein eingeschränktes Sensorenpotential und können auf 0, 1 oder 2 Sensoren begrenzt sein.
Wählen Sie aus allen unten aufgeführten nummerierten Feldern ihre Wunschoption aus, um einen kompletten Bestellschlüssel zu erstellen. 1 2 3 4
Bestellbeispiel LP28T0050D01M1111
1Baureihe LD28
2Verfahrweg
Txxxx Bitte Länge in mm angeben
3Antrieb
D01 1 mm Leitspindel (1)
D03 3 mm Leitspindel
D10 10 mm Leitspindel
D26 25,4 mm Leitspindel (2)
4Motor
M1111 Schrittmotor, NEMA 11, 1 Stack, 0,3 m Leitung (2)
M1112 Schrittmotor, NEMA 11, 1 Stack, 3 m Kabel (2)
M1321 Schrittmotor, NEMA 11, 3 Stack, hintere Welle, 0,3 m Leitung (2)
M1322 Schrittmotor, NEMA 11, 3 Stack, hintere Welle, 3 m Kabel (2)
M7122 Schrittmotor, NEMA 17, 1 Stack, hintere Welle, 3 m Kabel (1)
(1) D01 nicht verfügbar mit M7xxx
(2) D26 nicht verfügbar mit M1xxx
Verfügbarkeit Artikel
LP28LD28
Nummer Beschreibung
•• 002-2530-01Klemmpratzenset – mit (4) Klemmpratzen und (4) M3 x 12 Inbusschrauben
•• 002-2531-01Klemmpratzen Großpackung – nur (100) Klemmpratzen
• -002-2532-01 Sensorenmontageset – mit Montageclip, M2 Vierkantmutter und M2 x 5 Flachkopfschraube
•• 002-2533-01T-Nutenset – mit (10) M2 Vierkantmuttern
•• 002-2534-01 NEMA 17 Motoradapterset – mit Adapter, (4) M2,5 x 20 Inbussschrauben und (4) M3 x 16 Inbusschrauben
•• 003-3550-01Motor, NEMA 11 3-Stack, hintere Welle, 0,3 m Leitungen – für M1321 Option
•• 003-3550-08Motor, NEMA 11 1-Stack, 0,3 m Leitungen – für M111 Option
•• 003-3550-09Motor, NEMA 11 3-Stack, hintere Welle, 3 m Kabel – für M1322 Option
•• 003-3550-12Motor, NEMA 11 1-Stack, 3 m Kabel – für M1112 Option
•• 003-3551-01M2,5 x 60 Flachkopfschraube, zur Montage des NEMA 11 3-Stack Motors
•• 003-3551-02M2,5 x 40 Flachkopfschraube, zur Montage des NEMA 11 1-Stack Motors
•• 003-3558-03Kupplungsnabe, 5 mm Bohrung
•• 003-3560-01Zwischenscheibe
• -003-3743-07Sensor, Öffner, NPN, 3 m Kabel mit offenen Enden – für Option H2 oder L2
• -003-3743-05Sensor, Schließer, NPN, 3 m Kabel mit offenen Enden – für Option H3 oder L3
• -003-3743-08Sensor, Öffner, PNP, 3 m Kabel mit offenen Enden – für Option H4 oder L4
• -003-3743-06Sensor, Schließer, PNP, 3 m Kabel mit offenen Enden – für Option H5 oder L5
•• 003-3908-01M2 Vierkantmutter
•• 101-1564-01Klemmprofil
•• 101-1567-01NEMA 17 Motoradapter
•• C*LV171-02-10Motor, NEMA 17 1-Stack, hintere Welle, 3 m Kabel – für M7122 Option
•• 101-1564-01Klemmpratze 101-1567-01 NEMA 17 Motoradapter
• -002-2535-01Bandabdeckungs-Set mit 600 mm Abdeckband und den erforderlichen Montageteilen
ACHTUNG — VERANTWORTUNG DES ANWENDERS
VERSAGEN ODER UNSACHGEMÄßE AUSWAHL ODER UNSACHGEMÄßE VERWENDUNG DER HIERIN BESCHRIEBENEN PRODUKTE ODER ZUGEHÖRIGER TEILE KÖNNEN TOD, VERLETZUNGEN VON PERSONEN ODER SACHSCHÄDEN VERURSACHEN.
Dieses Dokument und andere Informationen von der Parker-Hannifin Corporation, seinen Tochtergesellschaften und Vertrags- • händlern enthalten Produkt- oder Systemoptionen zur weiteren Untersuchung durch Anwender mit technischen Kenntnissen. Der Anwender ist durch eigene Untersuchung und Prüfung allein dafür verantwortlich, die endgültige Auswahl des Systems
und der Komponenten zu treffen und sich zu vergewissern, dass alle Leistungs-, Dauerfestigkeits-, Wartungs-, Sicherheits- und Warnanforderungen der Anwendung erfüllt werden. Der Anwender muss alle Aspekte der Anwendung genau untersuchen, geltenden Industrienormen folgen und die Informationen in Bezug auf das Produkt im aktuellen Produktkatalog sowie alle anderen Unterlagen, die von Parker oder seinen Tochtergesellschaften oder Vertragshändlern bereitgestellt werden, zu beachten. Soweit Parker oder seine Tochtergesellschaften oder Vertragshändler Komponenten oder Systemoptionen basierend auf
technischen Daten oder Spezifikationen liefern, die vom Anwender beigestellt wurden, ist der Anwender dafür verantwortlich festzustellen, dass diese technischen Daten und Spezifikationen für alle Anwendungen und vernünftigerweise vorhersehbaren Verwendungszwecke der Komponenten oder Systeme geeignet sind und ausreichen.
AE – Vereinigte Arabische Emirate, Dubai
Tel: +971 4 8127100 parker.me@parker.com
AR – Argentinien, Buenos Aires
Tel: +54 3327 44 4129
AT – Österreich, Wiener Neustadt
Tel: +43 (0)2622 23501-0 parker.austria@parker.com
AT – Österreich, Wiener Neustadt (Osteuropa)
Tel: +43 (0)2622 23501 900 parker.easteurope@parker.com
AU – Australien, Castle Hill
Tel: +61 (0)2-9634 7777
AZ – Aserbaidschan, Baku
Tel: +994 50 2233 458 parker.azerbaijan@parker.com
BE/LU – Belgien, Nivelles
Tel: +32 (0)67 280 900 parker.belgium@parker.com
BR – Brasilien, Cachoeirinha RS
Tel: +55 51 3470 9144
BY – Weißrussland, Minsk
Tel: +375 17 209 9399 parker.belarus@parker.com
CA – Kanada, Milton, Ontario
Tel: +1 905 693 3000
CH – Schweiz, Etoy, Tel: +41 (0)21 821 87 00 parker.switzerland@parker.com
CL – Chile, Santiago
Tel: +56 2 623 1216
CN – China, Schanghai
Tel: +86 21 2899 5000
CZ – Tschechische Republik, Klecany
Tel: +420 284 083 111 parker.czechrepublic@parker.com
DE – Deutschland, Kaarst
Tel: +49 (0)2131 4016 0 parker.germany@parker.com
DK – Dänemark, Ballerup
Tel: +45 43 56 04 00 parker.denmark@parker.com
ES – Spanien, Madrid
Tel: +34 902 330 001 parker.spain@parker.com
FI – Finnland, Vantaa
Tel: +358 (0)20 753 2500 parker.finland@parker.com
FR – Frankreich, Contamine-sur-Arve
Tel: +33 (0)4 50 25 80 25 parker.france@parker.com
GR – Griechenland, Athen
Tel: +30 210 933 6450 parker.greece@parker.com
HK – Hong Kong
Tel: +852 2428 8008
HU – Ungarn, Budapest
Tel: +36 1 220 4155 parker.hungary@parker.com
IE – Irland, Dublin
Tel: +353 (0)1 466 6370 parker.ireland@parker.com
IN – Indien, Mumbai
Tel: +91 22 6513 7081-85
IT – Italien, Corsico (MI)
Tel: +39 02 45 19 21 parker.italy@parker.com
JP – Japan, Tokyo
Tel: +81 (0)3 6408 3901
KR – Korea, Seoul
Tel: +82 2 559 0400
KZ – Kasachstan, Almaty
Tel: +7 7272 505 800 parker.easteurope@parker.com
MX – Mexico, Apodaca
Tel: +52 81 8156 6000
MY – Malaysia, Shah Alam
Tel: +60 3 7849 0800
NL – Niederlande, Oldenzaal
Tel: +31 (0)541 585 000 parker.nl@parker.com
NO – Norwegen, Asker
Tel: +47 66 75 34 00 parker.norway@parker.com
NZ – Neuseeland, Mt Wellington
Tel: +64 9 574 1744
PL – Polen, Warschau
Tel: +48 (0)22 573 24 00 parker.poland@parker.com
PT – Portugal, Leca da Palmeira
Tel: +351 22 999 7360 parker.portugal@parker.com
RO – Rumänien, Bukarest
Tel: +40 21 252 1382 parker.romania@parker.com
RU – Russland, Moskau
Tel: +7 495 645-2156 parker.russia@parker.com
SE – Schweden, Spånga
Tel: +46 (0)8 59 79 50 00 parker.sweden@parker.com
SG – Singapur
Tel: +65 6887 6300
SK – Slowakei, Banská Bystrica
Tel: +421 484 162 252 parker.slovakia@parker.com
SL – Slowenien, Novo Mesto
Tel: +386 7 337 6650 parker.slovenia@parker.com
TH – Thailand, Bangkok
Tel: +662 717 8140
TR – Türkei, Istanbul
Tel: +90 216 4997081 parker.turkey@parker.com
TW – Taiwan, Taipei
Tel: +886 2 2298 8987
UA – Ukraine, Kiew
Tel +380 44 494 2731 parker.ukraine@parker.com
UK – Großbritannien, Warwick
Tel: +44 (0)1926 317 878 parker.uk@parker.com
US – USA, Cleveland
Tel: +1 216 896 3000
VE – Venezuela, Caracas
Tel: +58 212 238 5422
ZA – Republik Südafrika, Kempton Park
Tel: +27 (0)11 961 0700 parker.southafrica@parker.com
Europäisches Produktinformationszentrum
Kostenlose Rufnummer: 00 800 27 27 5374 (von AT, BE, CH, CZ, DE, EE, ES, FI, FR, IE, IL, IS, IT, LU, MT, NL, NO, PT, SE, SK, UK)
Technische Änderungen vorbehalten. Daten entsprechen dem technischen Stand zum Zeitpunkt der Drucklegung. © 2010 Parker Hannifin Corporation
Parker Hannifi n GmbH
Pat-Parker-Platz 1
Parker Hannifin GmbH Electromechanical Automation
Robert-Bosch-Straße 22
D-41564 Kaarst
D-77656 Offenburg, Germany
Parker Hannifin GmbH Vertriebs- und Servicezentrale
Pat-Parker-Platz 1
D-41564 Kaarst
Tel.: +49 (0)2131 4016 0
+49 (0)781 / 509-0
+49 (0)2131 / 4016-0
Fax: +49 (0)2131 4016 9199
+49 (0)781 / 509-98176
+49 (0)2131 / 4016-9199
parker.germany@parker.com
sales.automation@parker.com
www.parker-eme.com
www.parker.com
parker.germany@parker.com
www.parker.com
Ihr Parker-Handelspartner